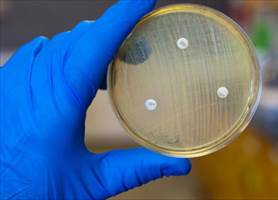

学习资料
教你如何正确选择和使用防护手套
发布人: 发布日期: 2019-07-08 浏览次数:
——转载自《浙江大学实验室安全》

在日常的实验过程中,手部是最易受到外部伤害的部位,或是割伤,或是烧伤,各种突发情况时有发生,那怎样保护我们细嫩的双手呢?老司机的回答是:戴防护手套。
但是!!!没有一对“万能通用”的手套。根据实验的需要选择正确合适的手套才是上上策。
实验室中,手套的常见作用有:防滑(麻面)、隔热、防机械损伤、养护(无粉)以及防化学腐蚀。
防护手套按材质可分为:天然乳胶、丁腈橡胶、天然橡胶、PVC(聚氯乙烯)、PVA(表面为聚乙烯醇涂层)、聚丁橡胶、丁基橡胶、皮革、布等。
来看下上述不同材质手套的真实面目吧!
实验室最常见的两种手套
1.天然乳胶
应用与优点:优异的防滑抓握性和良好的隔热性,适用于无油环境。对于水基化学品,如醇类,酸、碱水溶液具有较好的防护作用。舒适富有弹性,抗撕裂、刺穿、磨损和切割性能好。
缺点:对有机溶剂防护性能不好,不耐油;少量人群对乳胶蛋白过敏不可使用。

2.丁腈橡胶
应用与优点:是实验室里最为常见、必备的手套,能防止油脂(包括动物脂肪)、二甲苯、聚乙烯以及脂肪族溶剂的侵蚀,防渗水性,能抵抗酸、碱、酒精溶剂,灵活性、敏感性佳,具有耐磨性高、耐热性好、表面化学残留低等优点。
缺点:对很多酮类、芳香族化学品的防护性能较差,不能用于高温作业场所,也不能作为绝缘手套使用。
注:在操作硝酸等强氧化剂时穿戴丁腈手套是比较危险的,丁腈橡胶会在接触氧化性试剂的过程中被氧化,甚至导致燃烧。

实验室其它常用手套
天然橡胶
应用与优点:可用于清洗实验器皿、器械时使用。能对碱类、醇类以及多种化学稀释水溶液(如稀酸和稀碱)提供有效防护,能较好防止醛和酮的渗透。
缺点:对油脂和有机化合物的防护性较差,使用手套后,操作性不佳。

PVC
应用与优点:防化学腐蚀能力强,对大量水溶性化学物质具有防护作用,如:酸、碱、胺、过氧化物等。
缺点:不能防护有机溶剂。许多有机溶剂会使手套中增塑剂溶出,导致化学物质快速渗透;使用温度过高时,手套高温分解产生的氯乙烯(VCM)有毒。

PVA
应用与优点:有良好的耐化学、耐划破、耐磨损性,能对多种有机化学品提供高水平的防护,如脂肪族、芳香烃、氯化溶剂、碳氟化合物和大多数酮(丙酮除外)、酯类以及醚类等。
缺点:当接触到水时会很快分解,切勿在水或水基溶液中使用。

氯丁橡胶
应用与优点:在化学和石油化工行业应用广泛,对于石油化工产品、润滑剂具有很好的防护作用。同时对酸、碱、烃、醇、酚等有良好的防护作用。
缺点:耐寒性差,不宜低温使用。

丁基橡胶
应用与优点:特别适合用于处理有毒物质,可用于丙酮、乙腈、二甲基甲酰胺、二甲亚砜等的防护;对强氧化性浓酸以外的酸、氧化—还原溶液均有极好的抗耐性。
缺点:对于非极性溶剂的防护性较差。

布
应用:可用于器皿加热等操作过程中,可防中、低等机械磨损,加厚的可用于防热、抗寒。
缺点:仅用于一般性防护,不能用于化学防护。

皮革
应用与优点:适用于液氮操作、焊接作业等场合,对冷、热、火花飞溅、磨损、割、刺穿可进行一般性防护,防机械磨损性能较好。厚皮可防热,外层镀铝后可防高温及热辐射。
缺点:仅用于一般性防护,不能用于化学防护。

常见手套耐抗化学品的种类
手套物料 化学品 |
氯丁橡胶 |
PVC |
PVA |
天然橡胶 |
丁腈橡胶 |
苛形碱 |
S |
S |
NR |
S |
S |
无机酸 |
S |
S |
NR |
S* |
S* |
有机酸 |
S |
S |
NR |
S |
S |
醇类 |
S |
S |
NR |
S |
S |
酮类 |
S |
NR |
NR |
S |
NR |
酯类 |
F |
NR |
S |
NR |
F |
氯化溶剂 |
F |
F |
S |
NR |
F |
石油衍生的溶剂 |
F |
F |
S |
NR |
F |
甲醛 |
S |
S |
NR |
S |
S |
丙烯 |
S |
S |
NR |
S |
S |
二硫化碳 |
NR |
NR |
S |
NR |
F |
S:适合
F:普通,提供最低程度但足够的防护,但不宜与该化学品作长时间的接触
NR:不建议使用
S*:不适用于高浓度的硝酸或硫酸
(注:在选择耐抗化学品的手套时,应参照制造商的建议,尤以穿戴手套的手需要进入化学品为然。)
无菌手套的正确佩戴和除脱方式

选取尺码合适的手套,打开手套包,一手捏住手套翻折部分(手套内面)取出手套,对准五指戴上。注:没有戴无菌手套的手,只允许接触手套套口的向外翻折部分,不能碰到手套的外表面。
以戴着无菌手套的手指插入另一只手套的翻折内面,将手套戴好。已戴手套的手不可触碰另一只手的皮肤。
将手套翻折部翻回实验服袖口。

用一只手捏住另一只手套污染面的边缘将手套脱下。
戴着手套的手握住脱下的手套,用脱下手套的手捏住另一只手套清洁面(内面)的边缘,将手套脱下。
用手捏住手套的里面丢至废物容器内。
- 上一篇: 暑期实验室安全不容小觑
- 下一篇: 高校化学实验室安全事故“警示录”
